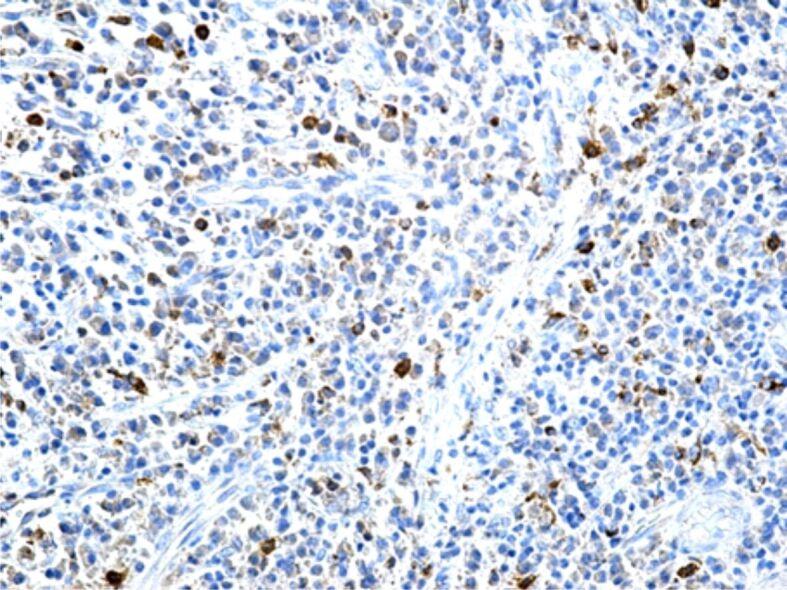
https://cdn.ncbi.nlm.nih.gov/pmc/blobs/6949/8597366/dd523cef9858/RJME-62-1-209-fig9.jpg
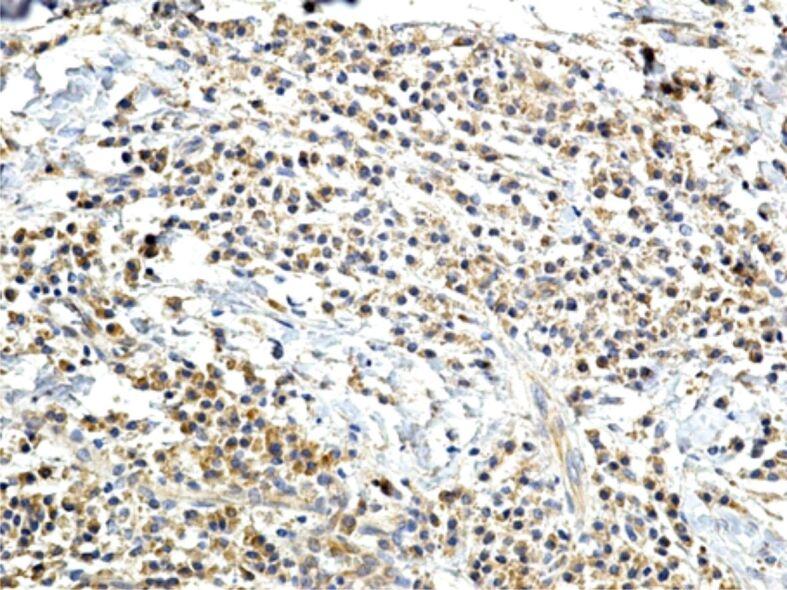
https://cdn.ncbi.nlm.nih.gov/pmc/blobs/6949/8597366/865bda59ad02/RJME-62-1-209-fig14.jpg
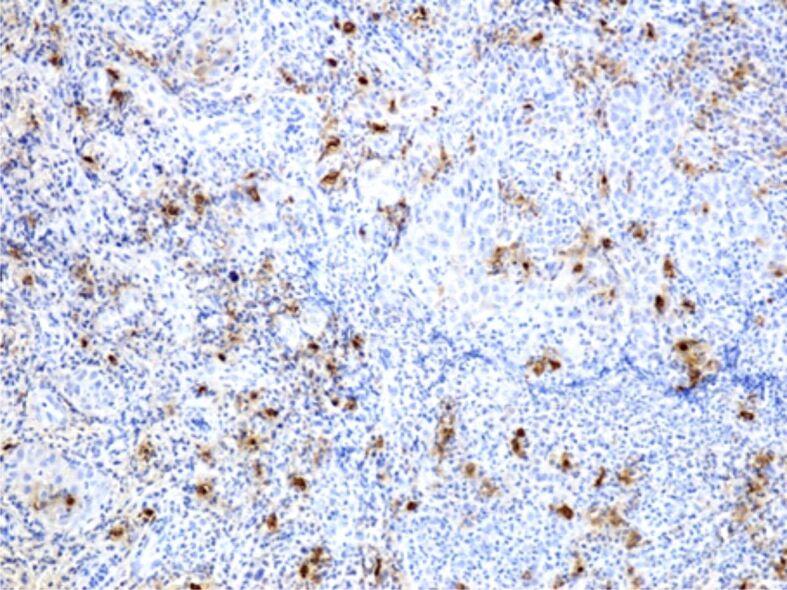
https://cdn.ncbi.nlm.nih.gov/pmc/blobs/6949/8597366/973f89eab13d/RJME-62-1-209-fig11.jpg

慢性吸烟者牙周变化的组织病理学和免疫组织化学研究。
Histopathological and immunohistochemical study of periodontal changes in chronic smokers.
机构信息
Department of Histology, University of Medicine and Pharmacy of Craiova, Romania;
出版信息
Rom J Morphol Embryol. 2021 Jan-Mar;62(1):209-217. doi: 10.47162/RJME.62.1.20.
Periodontal disease is a chronic inflammatory, multifactorial condition, that, in the absence of an early and adequate treatment, may lead to a progressive damaging of the alveolar tissues that support the teeth (periodontal ligament, cement and alveolar bone) followed by teeth mobility and, subsequently, their loss. Periodontal disease is one of the most common inflammatory disease affecting adult individuals all over the world, being considered a real worldwide pandemic. This disease may influence the progression of certain systemic diseases: diabetes mellitus, cardiovascular diseases, ischemic cardiomyopathy, myocardial infarction, stroke, neurodegenerative diseases, chronic kidney diseases, cancer, etc. The association between smoking and periodontal disease was described in numerous clinical and epidemiological studies, suggesting that products derived from tobacco burning may change the clinical aspects and the disease progression. The present study analyzed microscopically and immunohistochemically 58 periodontal fragments, from 50 patients, chronic smokers, clinically diagnosed with severe periodontitis. There were highlighted major changes in the gingival epithelium (epithelium thickening, acanthosis, intraepithelial edema, infiltrates of neutrophils or lymphocytes, epithelial necrosis), in the periodontal conjunctive tissue (more or less intense inflammatory infiltrates, microhemorrhages, vascular congestion, intense immunohistochemical expression for some matrix metalloproteinases). The periodontal changes may be the expression of both toxic factors present in tobacco smoke and due to the changes caused by tobacco in the microbial flora of the oral cavity.
牙周病是一种慢性炎症性、多因素疾病,如果不进行早期和充分的治疗,可能会导致支持牙齿的牙槽组织(牙周韧带、牙骨质和牙槽骨)进行性破坏,随后牙齿松动,最终导致牙齿脱落。牙周病是全世界成年人最常见的炎症性疾病之一,被认为是一种真正的全球性流行疾病。这种疾病可能会影响某些系统性疾病的进展:糖尿病、心血管疾病、缺血性心肌病、心肌梗死、中风、神经退行性疾病、慢性肾病、癌症等。大量的临床和流行病学研究描述了吸烟与牙周病之间的关系,表明烟草燃烧产生的产物可能会改变疾病的临床特征和进展。本研究通过显微镜和免疫组织化学分析了 50 名慢性吸烟者的 58 个牙周组织切片,这些患者均被临床诊断为严重牙周炎。结果显示,牙龈上皮(上皮增厚、棘皮病、上皮内水肿、中性粒细胞或淋巴细胞浸润、上皮坏死)和牙周膜结缔组织(或多或少强烈的炎症浸润、微出血、血管充血、某些基质金属蛋白酶的强烈免疫组织化学表达)出现了重大变化。牙周组织的变化可能是烟草烟雾中存在的有毒因素以及烟草引起的口腔微生物菌群变化的共同作用结果。